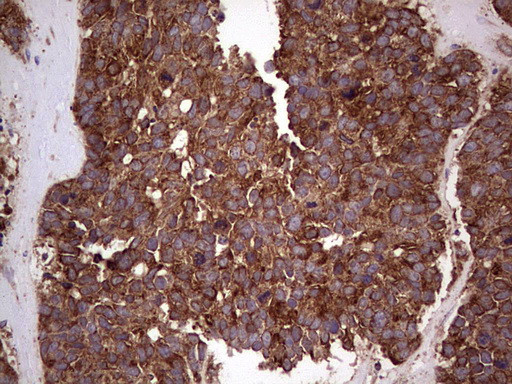
RET Antibody in Immunohistochemistry (Paraffin) (IHC (P))

Search
OriGene
RET Monoclonal Antibody (OTI1G1), TrueMAB™
{{$productOrderCtrl.translations['antibody.pdp.commerceCard.promotion.promotions']}}
{{$productOrderCtrl.translations['antibody.pdp.commerceCard.promotion.viewpromo']}}
{{$productOrderCtrl.translations['antibody.pdp.commerceCard.promotion.promocode']}}: {{promo.promoCode}} {{promo.promoTitle}} {{promo.promoDescription}}. {{$productOrderCtrl.translations['antibody.pdp.commerceCard.promotion.learnmore']}}
产品信息
TA805761
种属反应
宿主/亚型
分类
类型
克隆号
抗原
偶联物
形式
浓度
纯化类型
保存液
内含物
保存条件
运输条件
靶标信息
The receptor tyrosine kinase RET is a member of the cadherin superfamily. RET plays a crucial role in neural crest development, and can undergo oncogenic activation by cytogenetic rearrangement. RET transduce signals for cell growth and differentiation. Mutations in the RET gene are associated with the disorders multiple endocrine neoplasia, type IIA, multiple endocrine neoplasia, type IIB, Hirschsprung disease, and medullary thyroid carcinoma. Two transcript variants encoding different isoforms have been found for the RET gene. Additional transcript variants have been described for RET but their biological validity has not been confirmed.
仅用于科研。不用于诊断过程。未经明确授权不得转售。
篇参考文献 (0)
生物信息学
蛋白别名: Cadherin family member 12; Cadherin family member 12 (CDHF12); Cadherin related family member 16 (CDHR16); cadherin-related family member 16; CUX1/RET fusion; EC 2.7.10.1; ELKS; Hydroxyaryl protein kinase; hydroxyaryl-protein kinase; kinase Ret; Multiple endocrine neoplasia and medullary thyroid carcinoma 1; Oncogene RET; OTTHUMP00000216967; Proto-oncogene c-Ret; Proto-oncogene tyrosine-protein kinase receptor Ret; rearranged during transfection; receptor tyrosine kinase; RET ELE1; ret proto-oncogene (multiple endocrine neoplasia and medullary thyroid carcinoma 1, Hirschsprung disease); RET receptor tyrosine kinase; RET transforming sequence
基因别名: CDHF12; CDHR16; HSCR1; MEN2A; MEN2B; MTC1; PTC; RET; RET-ELE1; RET51
UniProt ID: (Human) P07949
Entrez Gene ID: (Human) 5979